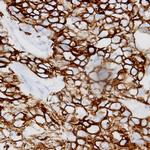
Cadherin (pan) Antibody in Immunohistochemistry (Paraffin) (IHC (P))
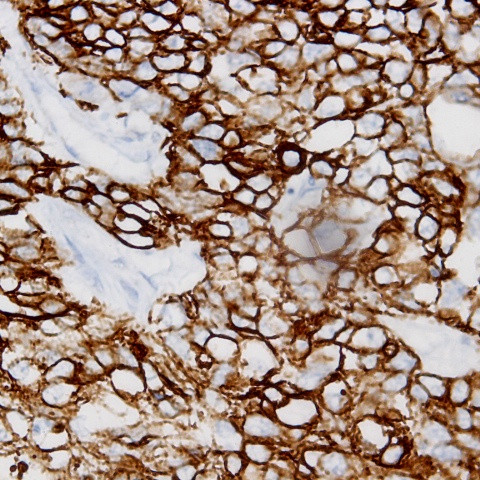
Cadherin (pan) Antibody in Immunohistochemistry (Paraffin) (IHC (P))

Search
AbboMax
Cadherin (pan) Polyclonal Antibody
{{$productOrderCtrl.translations['antibody.pdp.commerceCard.promotion.promotions']}}
{{$productOrderCtrl.translations['antibody.pdp.commerceCard.promotion.viewpromo']}}
{{$productOrderCtrl.translations['antibody.pdp.commerceCard.promotion.promocode']}}: {{promo.promoCode}} {{promo.promoTitle}} {{promo.promoDescription}}. {{$productOrderCtrl.translations['antibody.pdp.commerceCard.promotion.learnmore']}}
图: 1 / 1
Cadherin (pan) Antibody (500-2364) in IHC (P)
产品信息
500-2364
种属反应
宿主/亚型
分类
类型
抗原
偶联物
形式
浓度
规格
纯化类型
保存液
内含物
保存条件
运输条件
产品详细信息
Positive control: Cardiac tissue
Cellular location: membrane, junctions.
靶标信息
Pan Cadherin including CDH1, CDH2, CDH3, CDH4 protein belong to a family of transmembrane molecules that mediate calcium-dependent intercellular adhesion. Cadherins are involved in controlling morphogenetic movements during development and regulate cell surface adhesion through homotypic adhesion with the same cadherin species. N-cadherin's function is dependent on its association with the actin-cytoskeleton and is mediated through interactions between the C-terminal region of N-cadherin and the cytoplasmic catenin proteins. The stability of this association is regulated by phosphorylation and dephosphorylation of beta-catenin.This gene is a classical cadherin from the cadherin superfamily. The encoded protein is a calcium dependent cell-cell adhesion glycoprotein comprised of five extracellular cadherin repeats, a transmembrane region and a highly conserved cytoplasmic tail. The protein functions during gastrulation and is required for establishment of left-right asymmetry. At certain central nervous system synapses, presynaptic to postsynaptic adhesion is mediated at least in part by this gene product.
仅用于科研。不用于诊断过程。未经明确授权不得转售。
篇参考文献 (0)
生物信息学
蛋白别名: cadherin 1, E-cadherin (epithelial); cadherin 1, type 1, E-cadherin (epithelial); cadherin 2, type 1, N-cadherin (neuronal); cadherin 3, type 1, P-cadherin (placental); cadherin 4, type 1, preproprotein; cadherin 4, type 1, R-cadherin (retinal); cadherin e; Cadherin-1; Cadherin-2; Cadherin-3; Cadherin-4; cadherin-E; Cadherin-N; calcium-dependent adhesion protein, epithelial; calcium-dependent adhesion protein, neuronal; calcium-dependent adhesion protein, placental; CAM 120/80; CD324; CD325; CDw325; CDw325 antigen; cell-CAM 120/80; E-cadherin; E-cadherin 1; epididymis secretory sperm binding protein; Epithelial cadherin; N-cadherin; N-cadherin 1; Neural cadherin; Neural-cadherin; P-cadherin; Pan Cadherin; Placental cadherin; Placental-cadherin; R-CAD; R-cadherin; Retinal cadherin; unnamed protein product; Uvomorulin
基因别名: ACOGS; ADHD8; Arc-1; ARVD14; BCDS1; CAD4; CD324; CD325; CDH1; CDH2; CDH3; CDH4; CDHE; CDHN; CDHP; CDw325; ECAD; HJMD; LCAM; NCAD; PCAD; R-CAD; RCAD; UVO
UniProt ID: (Human) P12830, (Human) P19022, (Human) P22223, (Human) P55283
Entrez Gene ID: (Human) 999, (Human) 1000, (Human) 1001, (Human) 1002